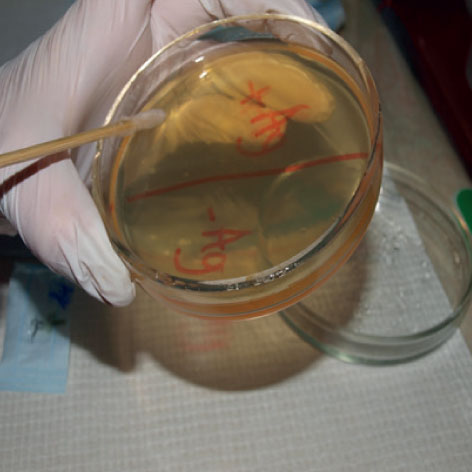
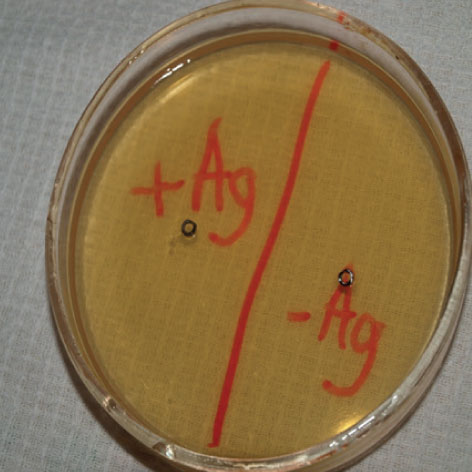
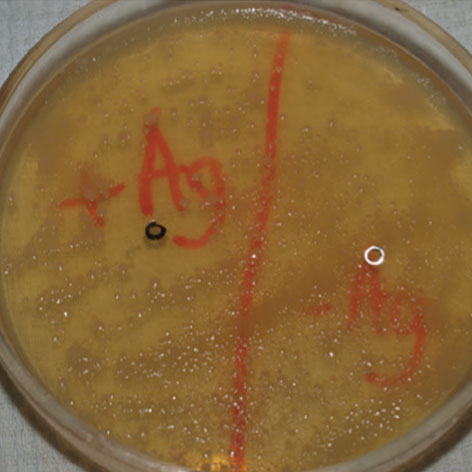

George Shubladze a member of Ukraine association of implantologists since 2009. Author of 28 scientific articles, 2 monographs, 9 patents, 12 rat. Proposals, assistant of the Child Surgical dentistry Department of Lugansk State medical University

Picture 3.





Picture 4.
Tested material was placed in a thermostat and kept it for 5 days at 37C. After extraction cups found intensive growth of colonies of yellow – white color uniformly over the entire Petri dish except silvered space around the abutment. Zone absence of bacterial growth is 1-1.5 cm The next issue that we face is the question of the pigmentation of the gum around the set silvered abutment. Everyone knows that silver oxide used in dentistry, intensely stained with hard and soft tissues of the mouth. For the prevention of this complication we offer only silvering switchings platform, hexagon and the abutment screw. For clinical confirmation of this fact we conducted experiments on rats. Next experience allowed to demonstrate the action of silver ions in vivo. For the operation two rats were used. First anesthetized rat on the left hind limb, we placed a sterile screw – plated plug and took a wound. On the right a screw plated too, but before it is wetted slurry of soft plaque and distilled water. The second rat was carried out similar manipulation with nonsilvered screws on the left – a sterile, right – infected by microorganisms, respectively. After 2 weeks we estimated a result. In an area with an infected nonsilvered screw swollen were observed limbs, flushing with suppuration and rejection, evidence of active inflammation process. In an area with a sterile screw nonsilvered observed weak swelling without signs of suppuration. In the area infected with silvered screw there is no inflammation, pigmentation the surrounding tissue is also observed.
Our experiments demonstrate the effectiveness and usefulness of the implant -abutment silvering. This method allows you to maintain microspace aseptic implant – abutment to reduce the likelihood of complications. However, it has many positive properties: bacteriostatic and bactericidal action (picture 5) is not pigmented oral mucosa; getting with active transport into cells of the mucosa, enhances the metabolism; is a very affordable method. Based on the foregoing we can safely assume that the proposed method can help our patients to extend the lifetime of the implant which is in its turn makes implantologists happy.


Picture 5.